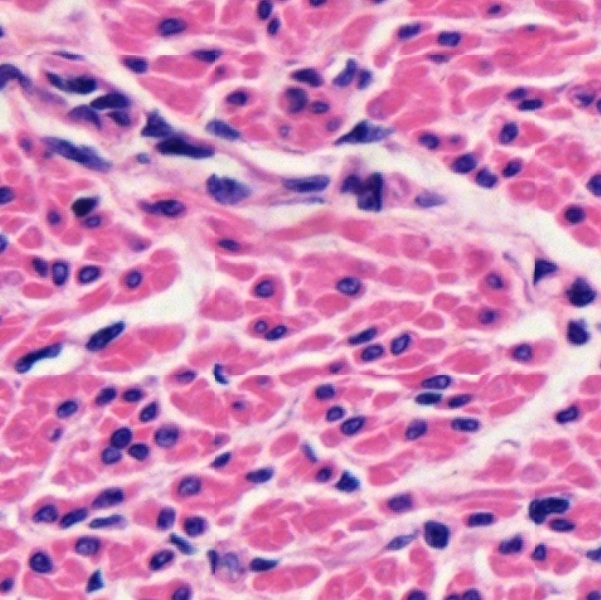
Fig. 6-19

In accordance with their contractile properties, three types of muscles exist in human body, namely, skeletal muscle, smooth muscle, and cardiac muscle. Each muscle type has its specific histological features in terms of cellular shape, nuclear location, intercellular junctions, and appearance of striation.
Skeletal Muscle
Skeletal muscle is a type of striated, voluntary muscle tissue attached to bones by tendons, making up 30-40% of the body’s mass. It is composed of bundles of muscle fibers controlled by the somatic nervous system to contract and execute voluntary movement, breathing, maintaining posture, and generating heat. Histologically, it is composed of elongated, multinucleated muscle cells, or known as muscle fibers. In a section prepared from human tongue muscle, stained by hematoxylin-eosin (Fig. 6-1), transverse (T), longitudinal (L), or oblique (O) sections of muscle fibers are found to be surrounded within collagenous tissue (C). Individual muscle fibers are grouped together into fasciculi (F) which are further grouped to form different muscle masses (M) separated by collagenous tissue (Fig. 6-2). The dense collagenous tissue enclosing the entire muscle mass is called epimysium (E). At higher magnification (Fig. 6-3), it is found that each muscle fasciculus is surrounded by a loose collagenous tissue called perimysium (P). The similar loose collagenous tissue surrounding individual muscle fibers are called endomysium (En).
Longitudinal section reveals that muscle fibers are unbranched, cylindrical cells with many flattened nuclei (N) located at fairly regular intervals just beneath the cytoplasmic membrane (Fig. 6-4). Muscle fibers are bound by collagenous tissue (C) together. Spindle-shaped fibroblasts (F) can be seen. Striations of some muscle fibers are clear enough to distinguish light band (I band) from dark band (A band). In the transverse section (Fig. 6- 5), perimysium (P) between two muscle fasciculi is found to be extended from the epimysium (E) enclosing the entire muscle mass. The endomysium can be identified by the presence of fibroblast (F), which is different from the nucleus (N) of muscle fiber (M) although both are located at the periphery of muscle fiber. In a teased preparation treated with silver impregnation (Figs. 6-6 and 6-7), striations and myofibrils, also known as myofilaments, can be seen clearly inside the individual muscle fibers.
The composition and relationship between epimysium (E) and perimysium (P) corresponding to muscle fasciculi (M) can be best illustrated in both transverse (Fig. 6-8) and longitudinal (Fig. 6-9) sections of skeletal muscle pieces stained by iodine hematoxylin. Epimysium is composed of dense irregular connective tissue while perimysium is extended from epimysium and is composed of loose connective tissue. At higher magnification of both transverse and longitudinal sections (Figs. 6-10 and 6-11), capillaries (C) can be in perimysium (P) and endomysium (En). Striations are clear enough to identify in some muscle fibers (Mf). Nuclei (N) of muscle fibers and fibroblasts (F) are located at the periphery of muscle fibers, but they are distinguishable by their shapes and staining.
Muscle-Tendon Junction
Body action is mainly executed by contraction of skeletal muscle to pull bones at joints. Skeletal muscle does not attach to the bone directly but through tendons. Muscle, myotendinous junction, and tendon form a functional, integrated system to perform skeletal movement. The interface between the muscle fibers (M) and the collagen fibrils of the tendon (T) can be observed in a section of muscle-tendon junction stained by hematoxylin and eosin (Fig. 6-12). At some locations, there is a clear distinction between muscular tissue and tendinous tissue (Fig. 6-13). At other locations, there seem to be an intermediate zone (I) between two tissues (Figs. 6-14 and 6-15). Within the intermediate zone, muscle tissue is found to be mingled with tendinous tissue (Fig. 6-15).
Clinically, muscle-tendon junction, or called as myotendinous junction, is one of the components of a myotendinous unit, which is the functional complex linking a muscle to a bone, primarily composed of the muscle, the myotendinous junction (where muscle and tendon meet), the tendon (which connects to bone via the enthesis), and the bone itself. The enthesis is the point of attachment where the tendon inserts into the bone. This myotendinous unit generates and transmits forces from muscle contractions to produce skeletal movement. The myotendinous junction is a critical, highly specialized region with a complex, interwoven structure designed to manage high stress and prevent injury.
Smooth Muscle
Smooth muscle is a type of muscle tissue that works automatically. It is mainly found in the walls of hollow organs, such as esophagus, gastrointestinal tract, respiratory tract, urinary tract, urinary bladder, male and female reproductive tracts, and uterus.
Smooth muscle cells are relatively small compared to skeletal muscle cells. Each cell is and has only one nucleus. Longitudinal sections of duodenum (Fig. 6-16) and uterus (Fig. 6-17) show that both muscle layers are composed of smooth muscle cells in an elongated spindle shape. Transverse sections of duodenum (Fig. 6-18) and uterus (Fig. 6-19) indicate that each smooth muscle cell has a centrally located nucleus. Despite of variation in arrangement in different organs, all muscle fibers are bound together in irregular branching fasciculi.
In the walls of blood vessels and lymph vessels, muscular layers are composed of vascular smooth muscle. Both medium-sized artery (Fig. 6-20) and vein (Fig. 6-20) have inner circular (IC) and outer longitudinal (OL) smooth muscle layers. In the skin (Fig. 6-22), the arrector pili (AP) is made of smooth muscle cells and are located near the sebaceous gland (SG). In the eyes, smooth muscles are seen inside the ciliary body with pigment cells (Fig. 6-23). Others like iris dilator muscle and iris sphincter muscle are also smooth muscles. More details will be further illustrated later in related chapters.
Cardiac Muscle
Cardiac muscle is a started muscle other than skeletal muscle. It is found in the cardiac wall to form heart muscle, known as myocardium. In a longitudinal section of the cardiac wall stained by hematoxylin and eosin (Fig. 6-24), cardiac muscle cells are seen to contain more than one nucleus with extensive cytoplasm branching to give an appearance of a continuous three-dimensional network. Cell nuclei (N) are found to be located centrally with visible but not clear striations (Fig. 6-25). Along with the extension of muscle fibers, there are vertical bars at certain intervals. These are intercalated discs (white arrows). In a transverse section, nuclei (N) are seen clearly to be located in the center of the cardiac muscle cells. Inside each cell there are many dots filled the cytoplasm. They are myofibrils. Fibroblasts (F) are also found in the spaces between cardiac muscle fibers.
A longitudinal section of the cardiac wall stained by iron hematoxylin is used to reveal striations and intercalated discs (Fig. 6-27). Not only the striations and intercalated discs (white arrows) are visible, branching of a cardiac muscle fiber (black arrow) are also shown (Figs. 6-28 and 6-29). The intercalated discs are specialized transverse junctions between cardiac muscle cells. They bind the cardiac cells, transmit contraction forces and provide areas of low electrical resistance for rapid spread of excitation throughout the myocardium.
Muscle Development
Muscle development, or myogenesis, begins in the mesoderm layer where progenitor cells called myoblasts proliferate and differentiate. Then, skeletal muscle, smooth muscle, and cardiac muscle follow different tracks to develop further. Skeletal muscle originates from somites, with myoblasts fusing to create multinucleated myotubes. Smooth muscle also develops from mesoderm, but its myoblasts do not fuse to form multinucleated cells. Cardiac muscle arises from the visceral mesoderm. Myoblasts do not fuse but instead form gap junctions to contract in a coordinated manner.
In sections of skeletal muscle taken from adult (Figs. 6-30, 6-31, and 6-32) and embryonic (Fig. 6-33) tissues stained by HE (Fig. 6-30), IdH (Fig. 6-31) and AZ (Figs. 6-32 and 6-33) stains respectively, striations are seen in adult muscle fibers but not in embryonic muscle fibers, which are diffused within the collagenous tissue . Cell nuclei are stained blue in HE and idH stained sections. Instead, they are stained red in Azur stained sections. Collagenous fibers are stained red in HE stained section, but blue in idH and AZ stained sections.
NOTE:
- Only those organelles visible under the light microscope are discussed here. It is suggested that to study all organelles visible under the electron microscope through your histology textbook and atlas.
- All photos used for discussion are taken from DSMH digital slides and other sources as follows:
H040020 Skeletal Muscle, ls. & cs., human, HE. (Figs. 6-1, 6-2, 6-3, 6-4, 6-5, 6-30)
H040021 Skeletal Muscle, ls. & cs., human, IdH. (Figs. 6-8, 6-9, 6-10, 6-11, 6-31)
H040024 Skeletal Muscle, teased., human, SI. (Figs. 6-6, 6-7)
H040030 Smooth Muscle, ls. & cs., human, HE.
H040040 Cardiac Muscle, ls. & cs., human, HE. (Figs. 6-24, 6-25, 6-26)
H040041 Cardiac Muscle, sec., human, IH, showing intercalated discs. (Figs. 6-27, 6-28, 6-29)
H040050 Muscle-Tendon Junction, ls., human, HE. (Figs. 6-12, 6-13, 6-14, 6-15)
H090230 Small Intestine Composite, cs. of three intestine portions, human, HE. (Figs. 6-16, 6-18)
H110220 Uterus, Follicular Phase, sec. showing follicular phase, human, HE. (Fig. 6-17, 6-19)
H060120 Large Vein, cs., human, HE. (Fig. 6-21)
H060140 Small Artery and Vein, cs., human, HE. (Fig. 6-20)
H080030 Scalp, showing hair follicles, sebaceous and sweat glands, human, HE. (Fig. 6-22)
H130030 Eye, sec., primate, HE. (Fig. 6-23)
Ho1295e Peritoneum, cs., human, AZ. (Fig. 6-32)
Ho141e Fetal Joint, ls., human, AZ. (Fig. 6-33) - Staining abbreviations and results:
AZ = Azan staining, is used to distinguish connective tissue from muscle. Nuclei are stained bright red; collagenous fibers are stained blue; muscle and erythrocytes are stained orange to red.
HE = hematoxylin and eosin, is used to stain cell nuclei blue and cytoplasm pink or red. Hematoxylin may also stain ribosomes and rough endoplasmic reticulum blue.
IdH = iodine hematoxylin, similar to iron hematoxylin, here is used to show striations.
IH = iron hematoxylin, here is used to show intercalated discs.
SI = silver impregnation, used to demonstrate neurons and processes in black or brown.